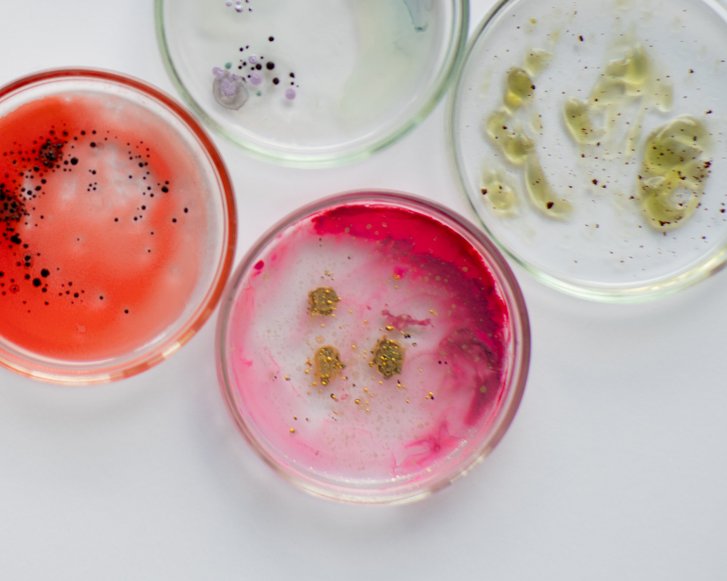
Resistente Bakterien: Schwarzer Phosphor statt Antibiotika

Resistente Bakterien: Schwarzer Phosphor statt Antibiotika
Ein australisches Forschungsteam hat ein Material vorgestellt, das eine neue Ära im Kampf gegen antibiotikaresistente Bakterien einleiten könnte. In Versuchen hat es 99 Prozent der Keime abgetötet.
Antibiotikaresistenzen sind ein bekanntes Problem in der Gesundheitsversorgung. Allein in der Europäischen Union sterben daran geschätzt jedes Jahr etwa 35.000 Menschen, und das Risiko nimmt zu. Denn nach wie vor werden in vielen Ländern Antibiotika unnötig verschrieben oder von den Patienten und Patientinnen nicht gemäß der Dosierungsanordnung eingenommen. Die Zahl der Bakterienstämme, die gegen eines oder mehrere Antibiotika resistent sind, wächst stetig – trotz der Appelle, mit Antibiotika-Verordnungen sorgsamer umzugehen.
Viele Forschende arbeiten daher an Alternativen. Wissenschaftler und Wissenschaftlerinnen vom australischen Royal Melbourne Institute of Technology (RMIT) und der University of South Australia (UniSA) haben jetzt eine Lösung vorgestellt: Sie setzen schwarzen Phosphor für die Behandlung von Infektionen und zur Wundheilung ein. Jetzt haben sie eine äußerst positive Zwischenbilanz gezogen.
Schwarzer Phosphor zerstört Bakterien effektiv
Schwarzer Phosphor ist die stabilste Form von Phosphor. Es handelt sich dabei um ein Mineral, das von Natur aus in vielen Lebensmitteln vorkommt. In ultradünner Form lässt es sich leicht mit Sauerstoff abbauen, was es ideal für die Abtötung von Mikroben macht. Denn wenn sich das Nanomaterial zersetzt, reagiert seine Oberfläche mit der Atmosphäre und setzt, vereinfacht gesagt, eine Kettenreaktion in Gang, an deren Ende Bakterienzellen zerstört werden.
In der vorliegenden Studie wurde die Wirksamkeit von nanodünnen Flocken aus schwarzem Phosphor gegen fünf gängige Bakterienstämme getestet, darunter E. coli und arzneimittelresistente Staphylokokken. Der schwarze Phosphor konnte nach Angaben des Forschungsteams mehr als 99 Prozent der Bakterienzellen beseitigen.
Beschleunigte Wundheilung
Erste Versuche zum Effekt auf die Wundheilung wurden ebenfalls durchgeführt: Ein Wissenschaftler trug dafür Nanoflocken des schwarzen Phophors täglich auf Wundinfektionen auf. Es kam zu einer beschleunigten Heilung, wobei sich die Wunden nach sieben Tagen zu 80 Prozent geschlossen hatten. Die Ergebnisse sind also vergleichbar mit den Effekten geeigneter Antibiotika. Das Wirkprinzip haben die Forschenden auch an einigen Bakterien-Stämmen getestet, die bereits gegen zahlreiche Antibiotika resistent sind – mit Erfolg.
Ein weiterer Vorteil des möglichen Einsatzes von schwarzem Phosphor liegt darin, dass er die Bakterien ohne Schädigung der gesunden Zellen abtötet.
Patentschutz beantragt
Der schwarze Phosphor lässt sich gut in gängige Materialien wie Plastik und Gele integrieren, weswegen er auch zur Herstellung von Wundverbänden genutzt werden könnte. Die Forschenden haben bereits Patentschutz für die schwarzen Phosphorflocken beantragt, einschließlich ihrer Verwendung in Wundheilungsformulierungen, wie Gelen.
Quellen:

Siehe auch:





